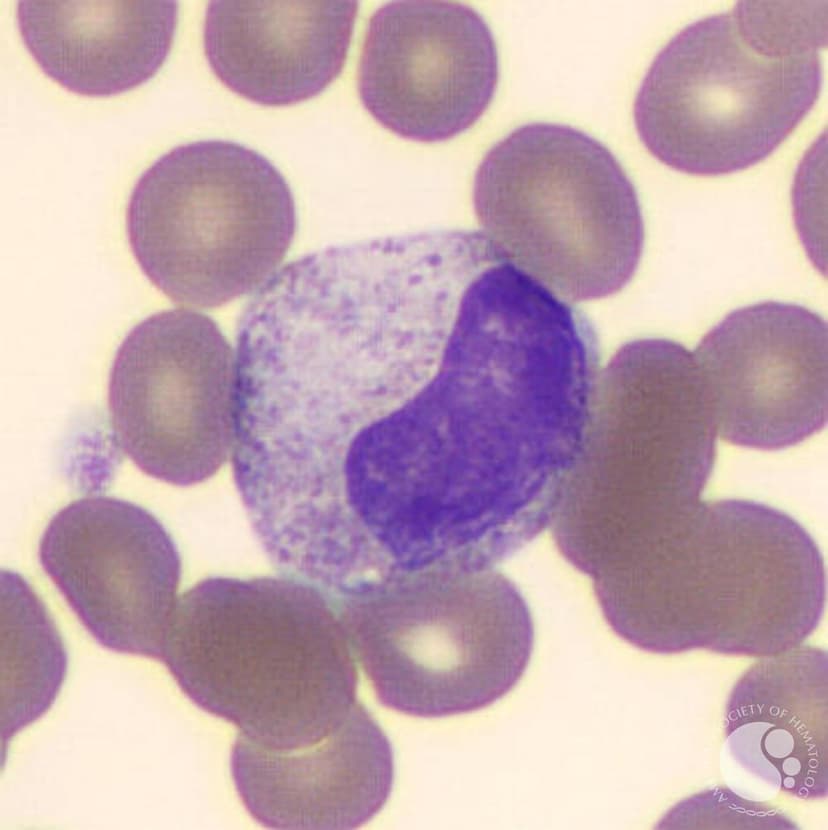
متامیلوسیت
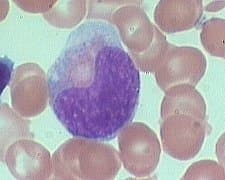
متامیلوسیت

متامیلوسیت
متامیلوسیت: اندازه سلول ۱۰ تا ۱۵ میکرون است. هسته لوبیایی شکل، آبی مایل به ارغوانی با کروماتین فشرده دارد و هستک دیده نمیشود. سیتوپلاسم دارای رنگ زمینهای صورتی، و گرانولهای ارغوانی است. سیتوپلاسم آن شبیه نوتروفیل بالغ است. بین ۱۰ تا ۲۵ درصد سلولهای مغز استخوان را تشکیل میدهد.
متامیلوسیتها کروماتین متراکمی دارند و دارای هستهای هستند که اندکی به سمت داخل فرورفته است. این میزان فرورفتگی کمتر از نصف قطر هسته است.
سیتوپلاسم، حاوی گرانولهای اختصاصی فراوان است و تعداد کمی از گرانولهای آزروفیلیک نیز ممکن است حضور داشته باشند.
متامیلوسیتها بهطور نرمال در خون محیطی دیده نمیشوند اما در عفونتها یا حالتهای التهابی و سایر شرایط واکنشی و نئوپلاستیک دیده میشوند.